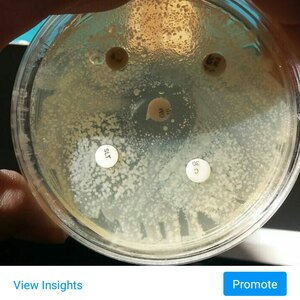
تصویر گالری

دکتر احمدی
پروانه کسب
هشتگرد
13 نظر4.9
جدول قیمتنظرهااطلاعات متخصصگالری تصاویر
نظرها
تعداد نظر135
4
3
2
1
4.9
درباره من
دکتر سید محمد مسعود احمدی به شماره نظام دامپزشکی ۲۰۳۳۶۰۲ ویزیت و درمان حضوری، مشاوره تلفنی، تامین دارو ، مکمل و خوراک و ملزومات حیوانات خانگی (اختصاصی پرندگان )و مزرعه ( اسب، نشخوارکنندگان کوچک و بزرگ) آدرس :کوهسار بلوار امام خمینی داروخانه دامپزشکی دکتر ریاضی
تخصص های دکتر احمدی
گالری تصاویر